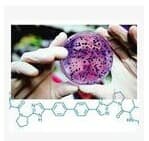

据徐州医药专家表示:09年美国哈佛大学肝脏医学研究人员森口尚史等人结合应用一种基因和两种化学物质,成功使实验鼠约90%的肝癌细胞恢复成正常细胞。
综合当地媒体报道,研究人员首先培育出患有肝癌的实验鼠。然后,他们使用腺病毒将HNF4α基因导入肝癌细胞。结果显示,HNF4α的作用一旦降低,癌症的恶性程度就会提高。
研究人员还向实验鼠的肝癌部位注射了两种化学物质,这两种物质可以提高癌细胞转变成正常细胞的能力。给药后60天,8只实验鼠全部存活,它们体内肝癌细胞有85%至90%转变成正常细胞,癌细胞特有的染色体异常也消失了。而未经治疗的其他8只实验鼠在实验开始后3周内全部死于肝癌。
研究人员今后计划确认这种新方法的安全性,争取能用此方法治疗肝癌患者。
阅读下一篇
佳辰研制的治疗性乙肝疫苗进入临床了吗